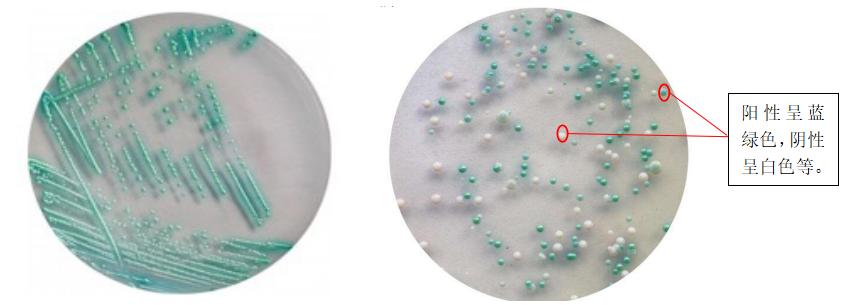
白色念珠菌感染是真菌感染吗,真菌细菌感染鉴别诊断

在日常生活中,真菌感染是比较常见的现象,其中又以念珠菌病(又称假丝酵母菌病)最为常见。念珠菌的种类很多,但真正能对人致病的却不多,其中白色念珠菌是一种致病力强,可以造成人体体表或深部感染的真核微生物。
白色念珠菌是寄生在人体皮肤、口腔、胃肠道、阴道等黏膜上的正常菌群。当人体免疫功能出现异常或正常菌群失调时,白色念珠菌可引起全身系统性感染、粘膜皮肤感染、下呼吸道感染以及泌尿系统感染等疾病[1]。研究表明,在亚洲引起深部真菌病的病死率高达30% 左右[2]。
在我国,2020年版《中华人民共和国药典》将白色念珠菌作为微生物检验真菌的代表菌。一旦药品中检出白色念珠菌即可确认该药品被真菌污染。
那么,如何检测产品被真菌感染?下面同小编一起来《中华人民共和国药典》中寻找答案吧。
首先,在做正式试验前,应进行方法适用性试验,以确认所采用的方法适合于该产品的控制菌检查。
具体操作如下:
1.进行菌液制备。将白色念珠菌接种于沙氏葡萄糖琼脂培养基上或沙氏葡萄糖液体培养基中,在20-25℃条件下,培养 2-3天,再将上述培养物用pH 7.0的无菌氯化钠-蛋白胨缓冲液或0.9%无菌氯化钠溶液制成适宜浓度的菌悬液;
2.按控制菌检查法取规定量供试液及不大于lOOcfu的试验菌接入规定的培养基中;
3.在规定的温度和最短时间下培养,应能检出白色念珠菌试验菌相应的反应特征。
为确认试验条件是否符合要求,应进行阴性对照试验。阴性对照试验应无菌生长,如阴性对照有菌生长,应进行偏差调查。方法适用性试验结果判断见图1。

图1:方法适用性试验结果判断
其次,按经方法适用性试验确认的方法进行供试品的控制菌检查。
具体操作流程见图2。

图2:供试品的控制菌检查流程
说明:白色念珠菌在沙氏葡萄糖琼脂培养基上生长的菌落呈乳白色,偶见淡黄色,表面光滑并伴有浓酵母气味。随着培养时间的增加菌落增大,颜色变深、质地变硬或有皱褶(见图3);白色念珠菌在显色培养基平板上呈现蓝绿色(见图4)。

图3:白色念珠菌在沙氏葡萄糖琼脂培养基上的形态
图4:白色念珠菌在显色培养基平板呈蓝绿色
最终结果判断:若沙氏葡萄糖琼脂培养基平板上有疑似菌落生长,且疑似菌在念珠菌显色培养基平板上生长的菌落呈阳性反应(呈蓝绿色),则应进行适宜的鉴定试验,确证是否为白色念珠菌;
若沙氏葡萄糖琼脂培养基平板上无菌落生长,或虽有菌落生长但鉴定结果为阴性,或疑似菌在念珠菌显色培养基平板上生长的菌落呈阴性反应,则判断供试品未检出白色念珠菌。
近几年,关于白色念珠菌引起的感染报道日益增加,掌握正确的检测方法,严格控制易污染源头,提高人体免疫力,对预防白色念珠菌感染具有重要意义。